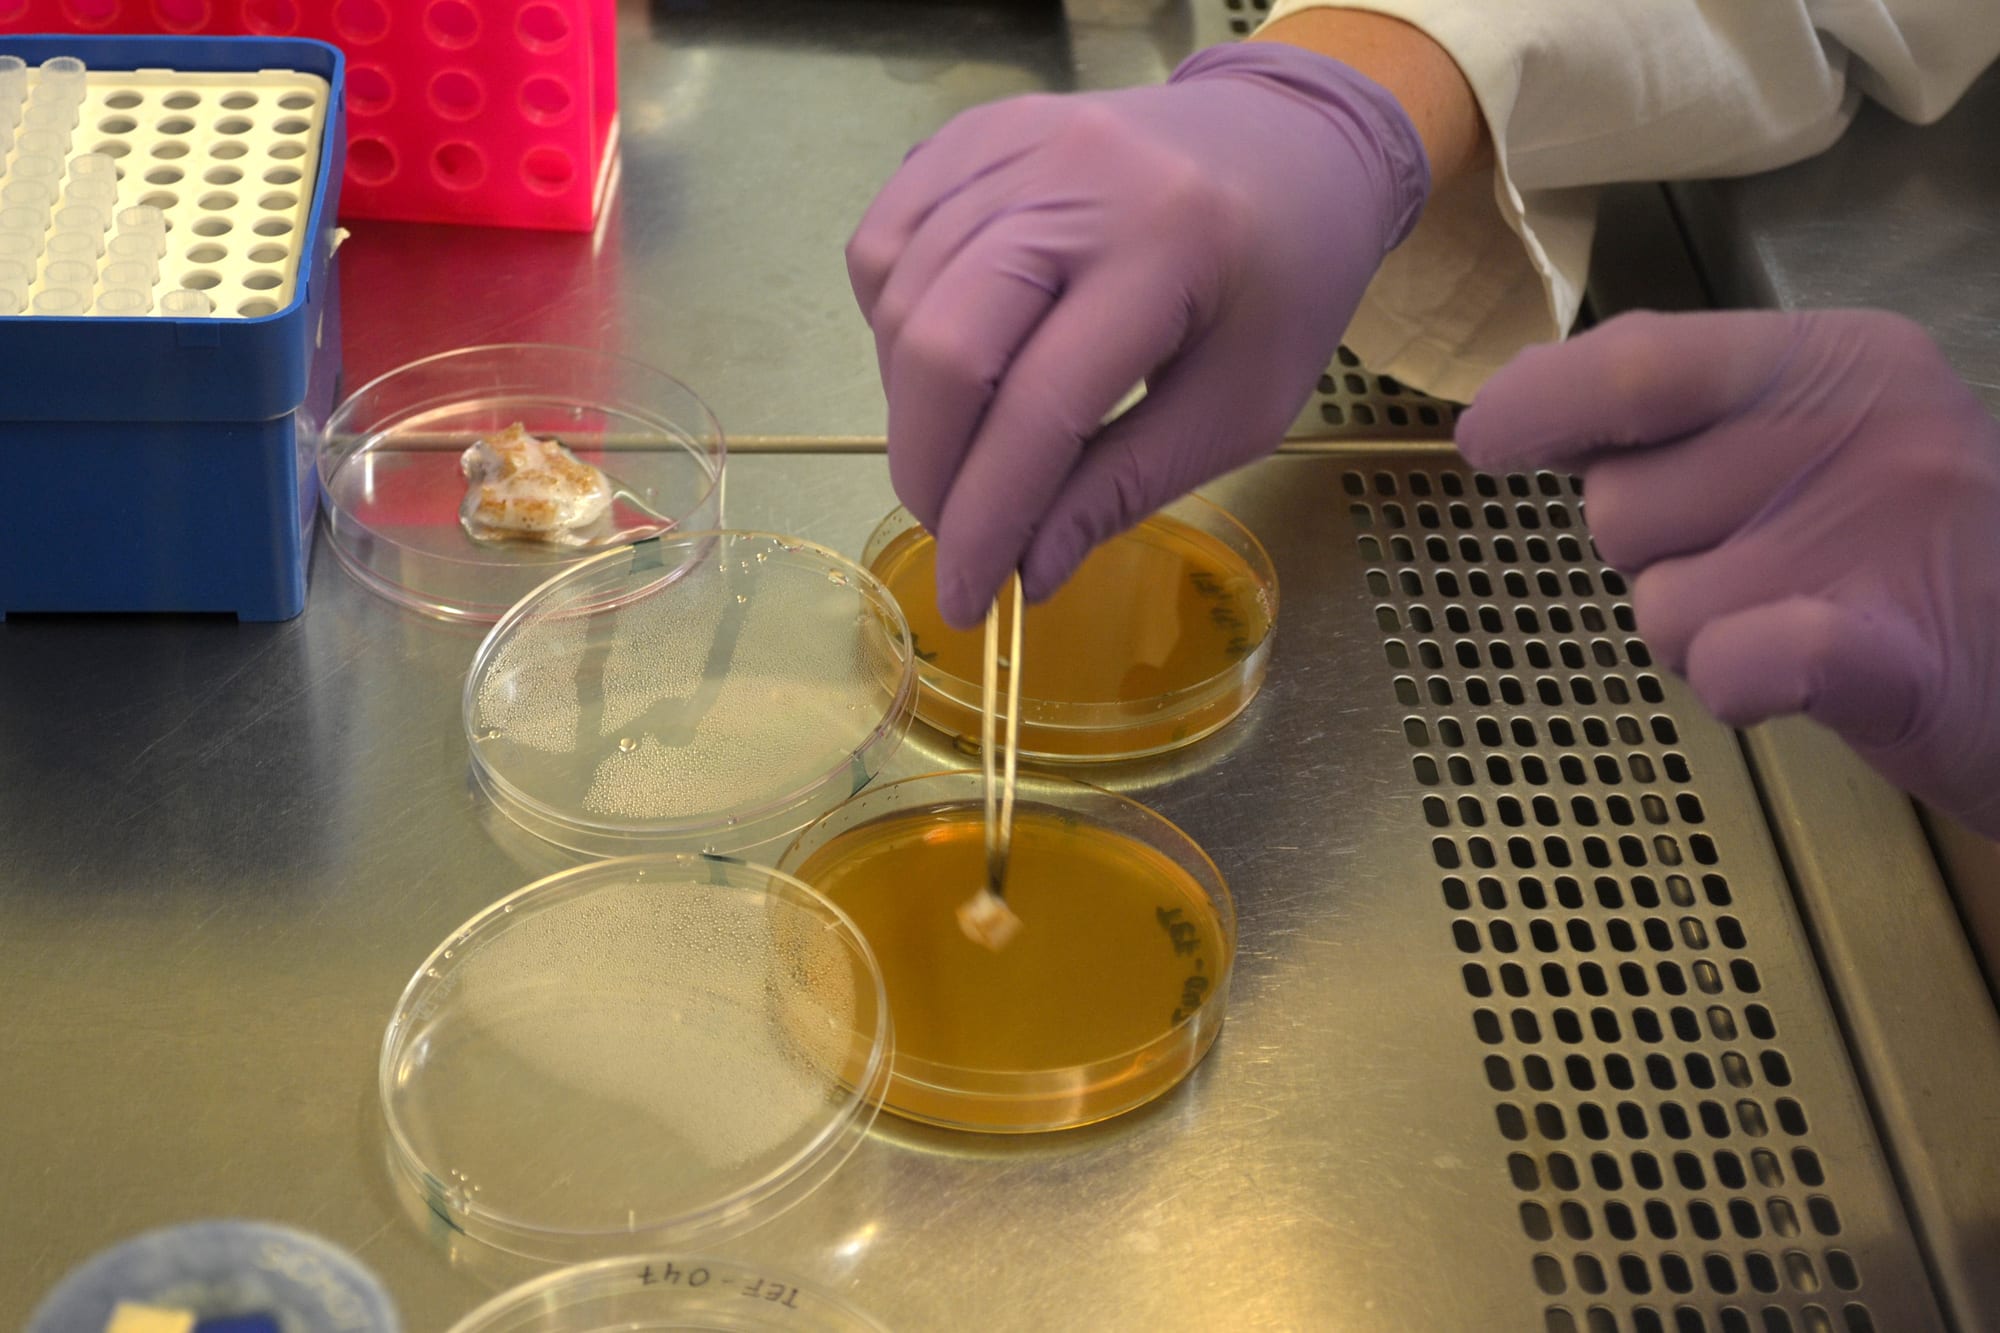

Mind the Fungi
Walk & Talks
Theresa Schubert and TU Berlin
The Walk & Talks were public events and integral parts of Mind the Fungi, to explore with citizen scientists the potential of sustainable biomaterials from fungi. Artist Theresa Schubert led the events offering diverse perspectives on the forests and their cultural meaning including performances. Together with scientists from the Institute for Biotechnology, TU Berlin, she guided the groups through Tegel forest and the forests of the Briesetal, Brandenburg in search of tree mushrooms and lichens.
As a second part Bertram Schmidt and Carsten Pohl from the Dept. of Applied and Molecular Microbiology, TU Berlin, showed the participants how to preserve the samples for further study. Participants inoculated Petri dishes with samples for cultivation. The samples are essential part of the research project’s stem collection, combining cutting edge biological research, citizen science and artistic research.
Theresa Schubert is a Berlin-based artist exploring unconventional visions of nature, technology and the self. She holds a PhD in Media Art from Bauhaus-University Weimar. She investigates the role of creativity and collaboration from a posthuman perspective. Her work combines audiovisual and hybrid media to conceptual and immersive installations or performances. That includes organic matter and living organisms, algortihms and artificial intelligence becoming part of the art work not just as material but meaningful co-creators. Her works question the relation of humans to their environment and evolvement of matter and meaning beyond the Anthropos. More recently, she works with UHD video environments and 3D Laser Scanning to challenge modes of perception and question the human-machine relationship in hypertech/ Cyborg societies.